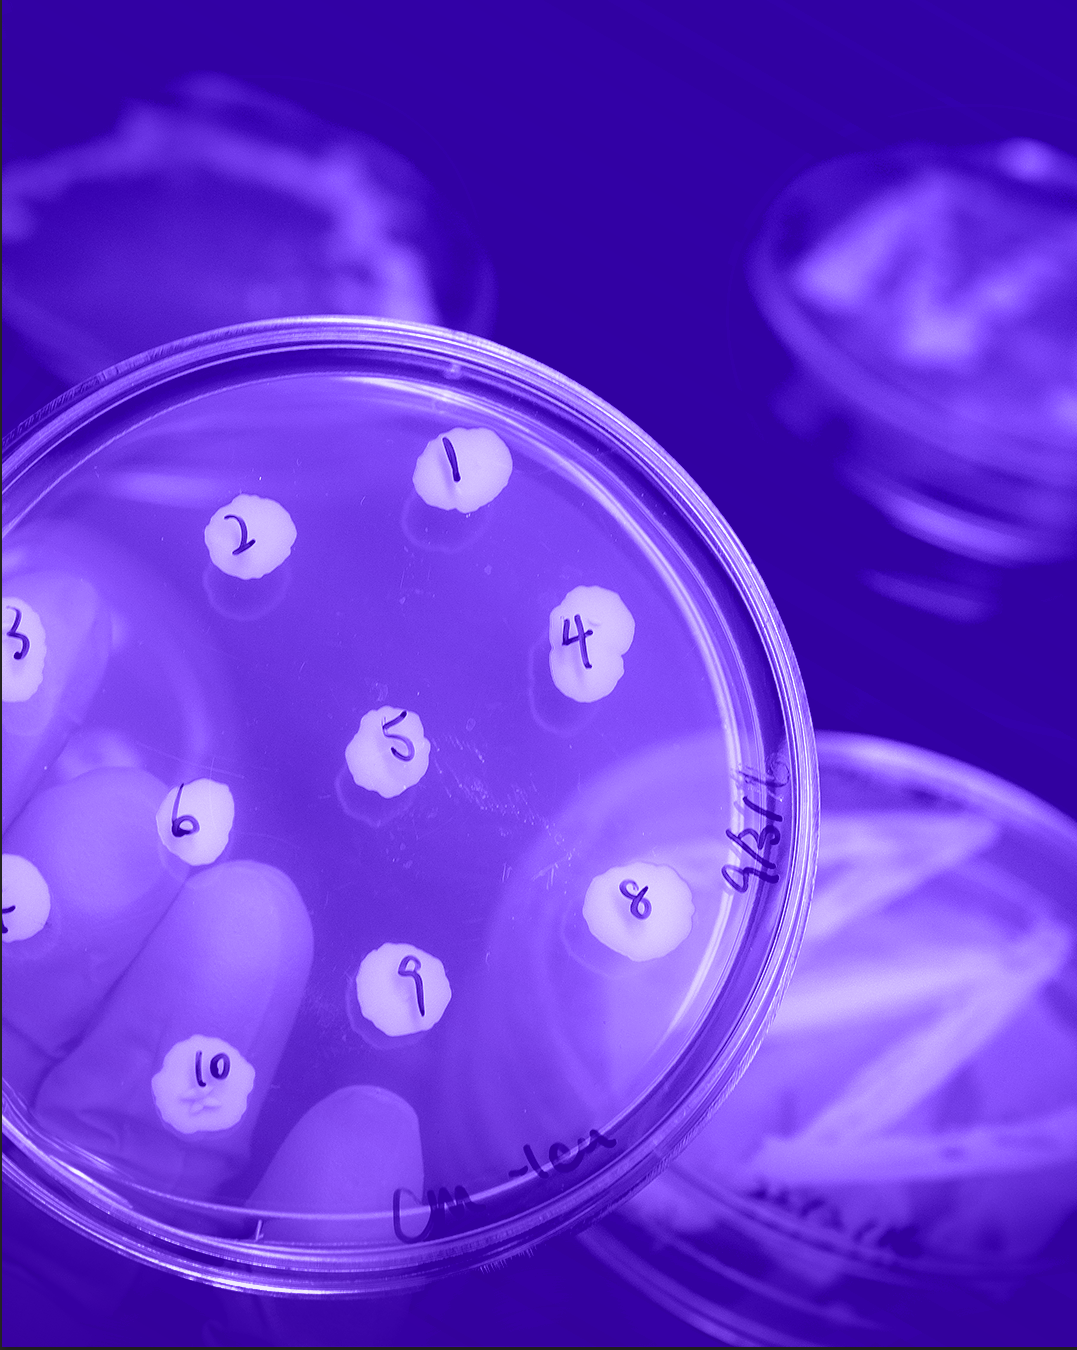

Free from microbiological contamination
Elyxeer 30.5 is a state-of-the-art supplement developed by scientists. Thanks to the unique PreTiSy® technology, your body will receive precise doses of the necessary substances at the ideal time and with a intelligent synergistic effect .
Precision
77 bioactive substances in precisely defined doses



Timing
Dosage respecting the body's circadian rhythm

Synergy
Layered nutrients for maximum effectiveness
Premium branded ingredients
Ingredients of the highest quality and purity, tested and certified through third-party laboratory testing.
production and development fully under control
Cleaner, Safer, More Efficient .

Laboratory-Tested Quality of All Ingredients
All key raw materials contained in Elyxeer 30.5 undergo a series of laboratory tests to verify the purity of the mixture, the content of active substances, and the absence of unwanted components. We combine modern analytical methods and test substances in several ways.
We use high-performance liquid chromatography (HPLC) and UV–VIS spectroscopy to accurately determine the content of active substances or extracts in the mixture. ICP-MS (inductively coupled plasma mass spectrometry) and AAS (atomic absorption spectrometry) are used to verify the absence of heavy metals, while GC-MS (gas chromatography coupled with mass spectrometry) is used to detect pesticides and organic solvent residues in plant extracts.
As a result, you receive a product whose quality is supported by specific laboratory data, and whose scope of testing not only meets but far exceeds legislative and market standards.

Microbiologically Tested for Purity and High Live Culture Content
At Elyxeer 30.5, we dedicate a separate layer of control to microbiology. Collagen, creatine, plant extracts, and vitamin ingredients undergo microbiological testing to verify their purity and compliance with strict requirements, ensuring that only top-quality raw materials make it into the final product.
For the probiotic ingredient, we perform inoculations on culture media to verify a sufficient number of viable cultures (CFU) of LactoSpore® Bacillus coagulans.
Verified Stability from Production to Consumption
Some bioactive substances are highly sensitive to time, temperature, and oxygen, which is why at Elyxeer 30.5 we protect them at every step, from selecting the highest-quality raw material forms, through controlled production and storage conditions, to final packaging.
We continuously test the stability of sensitive ingredients and package the mixture in individual single-dose sachets that protect the substances from light and oxygen until the final moment before consumption. Thanks to this approach, we maintain the declared amount and effectiveness of sensitive substances throughout the product’s shelf life.
Elyxeer 30.5: complex science-backed supplement
Elyxeer 30.5 is a comprehensive, scientifically designed system that smartly combines 77 carefully selected ingredients into two precisely dosed phases, morning and evening. Both phases come in a single package. Morning Elyxeer is designed to support optimal functioning throughout the day, while Evening Elyxeer replenishes nutrients as the body naturally slows down and prepares for rest. Together, they form a thoughtful, interconnected system built on the synergy of vitamins, minerals, collagen, and other bioactives, respecting and supporting the body’s natural rhythm.
Food supplement with sweeteners. The package contains 30 sachets of the morning mixture (7.5g/pcs) and 30 sachets of the evening mixture (8.2g/pcs). Total content: 471g.
Usage:
-
Morning Elyxeer: 1 sachet daily. Mix in 250–300 ml of water and drink, ideally in the morning with a light breakfast.
- Evening Elyxeer: 1 sachet daily. Mix in 250–300 ml of water and drink ideally about 1-2 hours before bedtime.
Packaging:
With a one-time purchase, you will always receive individual sachets packed in tubes, along with a stylish glass shaker. If you choose a subscription, this packaging will be included in your first order. From the second month onwards, you will regularly receive convenient individual sachets, making it easy to refill your containers.
Warning:
Food supplement with sweeteners. Does not replace a varied diet and a healthy lifestyle. Keep dry and out of reach of children. Not suitable for pregnant and breastfeeding women and children. If you are taking medication or have health problems, consult your doctor before use. Do not use if you are allergic to any of the ingredients. Morning Elyxeer contains omega-3 (allergen: fish). Evening Elyxeer contains fish collagen (allergen: fish).
Elyxeer 30.5 is a member of Science Studio Ltd.









